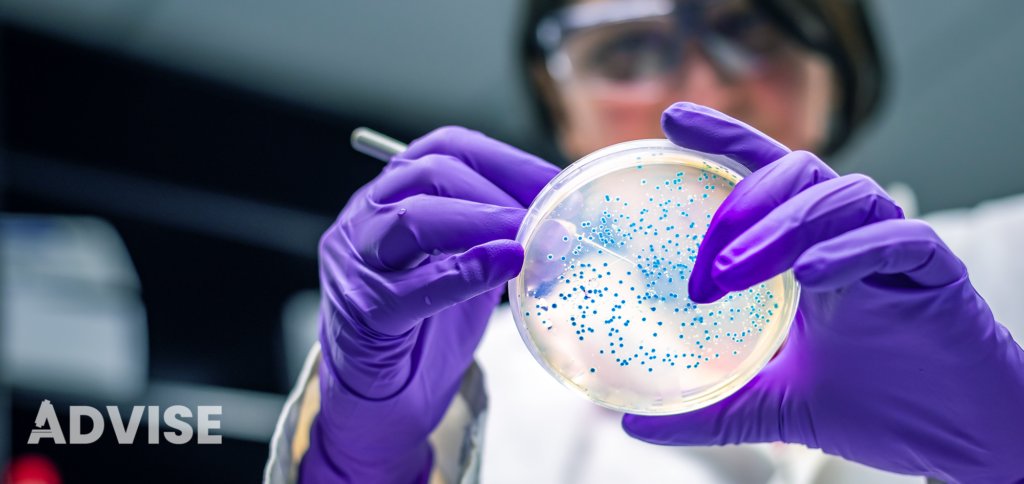
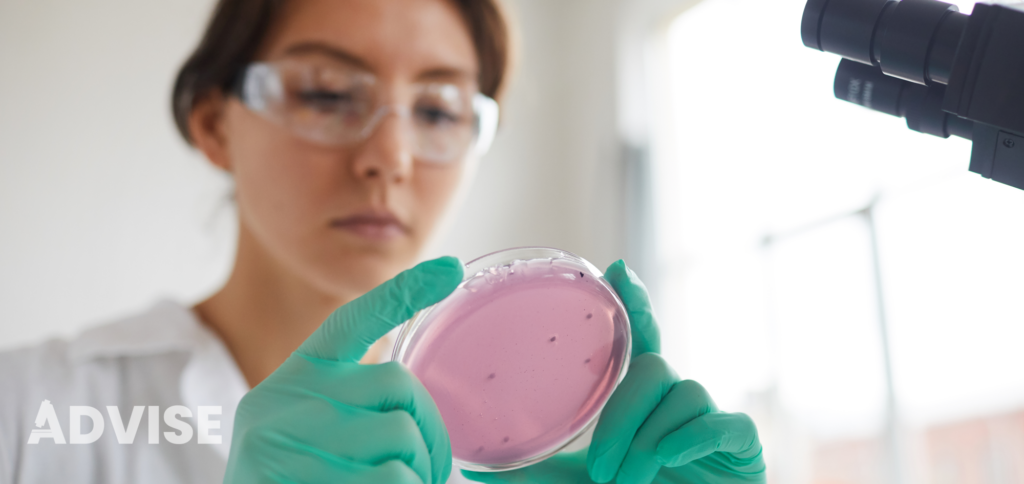

ADVISE is creating a dynamic educational environment organizing dissemination events aimed to introduce 5 trainees and their peers to antiviral research experts in academia and biopharma companies and establish virtuous networks.
One of the goals of the project is to propose an “Advanced training in bio-pharma development antiviral research“: the project plans to perform an advanced training through the transfer of knowledge embedding the trainees in an up-to-date applied research case study.
Trainees will be exposed to an entire research process, from experimental design and data collection to analysis and interpretation, giving them a practical understanding of research methodologies. This hands-on experience will allow the trainees to apply theoretical knowledge in a practical setting, honing their technical and problem-solving skills.
Trainees will be required to maintain thorough documentation of their experiments, including protocols, observations, and any modifications made during the process, and to regularly present their results. Such approach will contribute to a more engaging and impactful learning experience.
The chosen case study is focused on the pharmacologic stimulation of innate immunity to achieve viral inhibition, an attractive and innovative strategy to the development of broad-spectrum antiviral agents. Specifically, the target of the research training will be hSTING, a signaling protein essential for activating the innate immune defences (including type I interferons, IFNs, and pro-inflammatory cytokines) following recognition of cytosolic viral DNA, bacterial secreted cyclic dinucleotides (CDNs) or DNA cell anomalies.
Recently, hSTING agonists have been reported to elicit antiviral activity against SARS-CoV-2, HBV, HSV, and flaviviruses, demonstrating that hSTING is a validated and promising drug target against viral infections.
In this scenario, UNICA researchers recently identified some benzofuran derivatives (BZF) with promising antiviral activity against Coronaviruses. Docking studies suggest that the binding can be in a ratio 2:1 agonist/hSTING.
Hence, inspired by these findings and literature data, ADVISE will involve the trainees in a case-study dedicated to the design and synthesis of novel BZF dimers, as well as other classes of hSTING agonists, and their biological testing as broad-spectrum antiviral agents.

The Advanced training in bio-pharma development antiviral research will be organized in main activities and sub-activities:
– Research Training in drug design and synthesis of hSTING agonists: trainees will be guided in the systematic progression from the conceptualization and design of promising hSTING agonists to their synthesis, purification, and thorough characterization of synthesized molecules.
Trainees will employ also advanced models and algorithms to predict the Absorption, Distribution, Metabolism, and Excretion (ADME) properties of the compounds designed in the initial phase.
Computational insights will guide compounds prioritization for synthesis through the whole project. Trainees will be involved in the synthesis of the most promising designed molecules. The emphasis will be not only on the synthesis it self but also on scalability and reproducibility of the processes.
– Research Training in biochemical and cellular studies of hSTING agonists: this activity is planned to guide trainees to experimentally verify whether synthetized molecules are effective hSTING ligands employing binding assays, and confirm that they induce innate immunity STING-dependently employing cell-based assays. It includes the biochemical evaluation of the binding of molecules to hSTING, the evaluation of the of molecules on hSTING activation in cell-based assays, the training in biochemical and cellular assays on hSTING response.
At the end of this activity the trainees will acquire fundamental techniques in protein purification, including plasmid purification and expression in bacteria, handling protein purifying instruments. They will also learn how tomanipulate cell culture and to perform gene-reporter luciferase assays following the application of the already developed protocols.
– Research training on viral replication inhibition studies by hSTING agonists: during this activity trainees will verify hSTING ligands antiviral effects on two main viral families: RNA (Coronaviruses) and DNA (Herpesviruses) viruses. Trainees will use cell-based antiviral assays for the evaluation of the compounds’ protective effects. This research activity include: evaluation of the antiviral activity properties of the hSTING agonists, evaluation of efficacy of identified hSTING agonists on RNA virus replication, evaluation of efficacy of identified hSTING agonists on DNA virus replication, training in cell transcriptomics signal transduction imaging.
This activity is focused on guiding trainees in handling RNA and DNA viruses: they will be instructed to manipulation of culture cells for the production and amplification of viral strains and acquire skills in determining viral concentration in a solution through virus titration assays. They will also learn to assess cytopathic effect, which is crucial for determining viral activity, replication speed, and pathogenicity. These techniques are vital to understand viral replication dynamics and subsequently assessing the efficacy of antiviral treatments.
